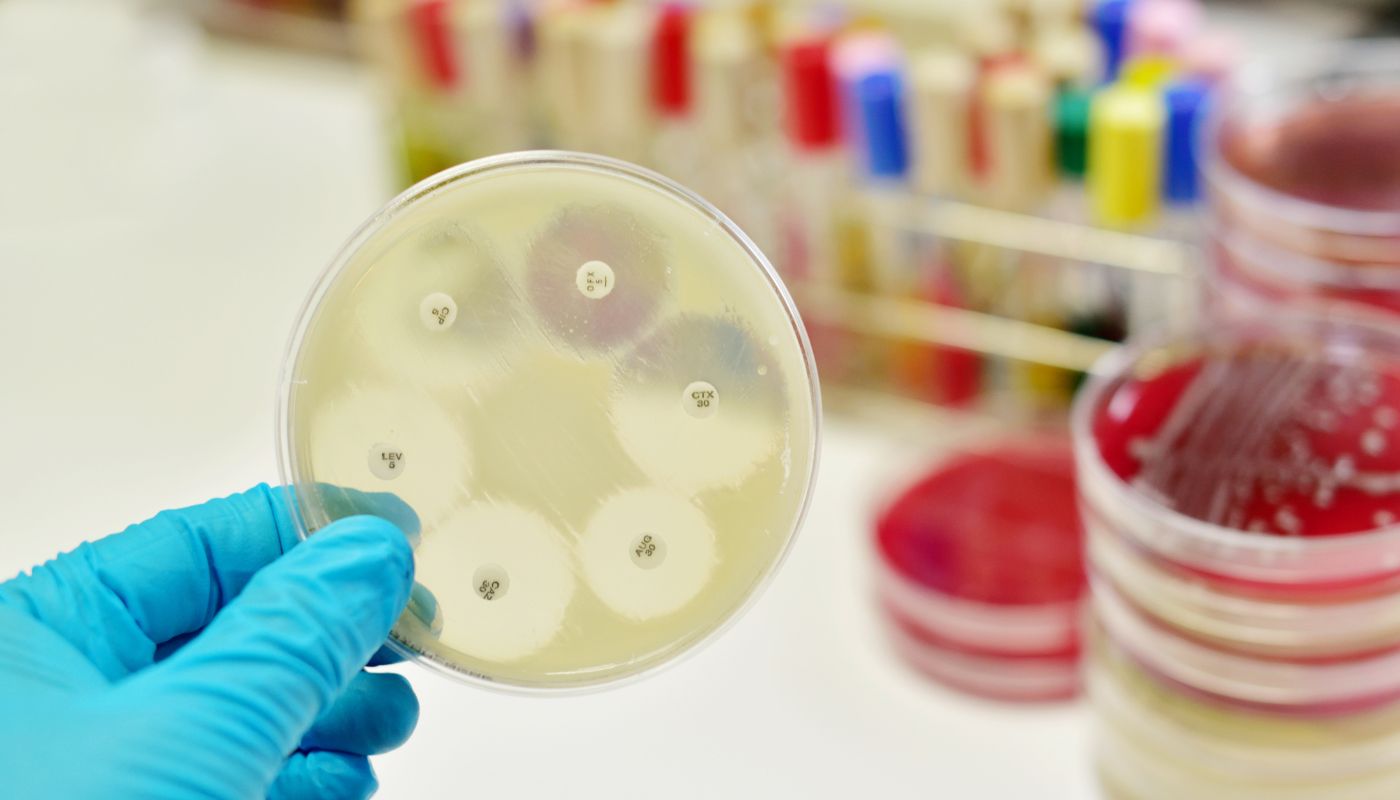

About Natureza® Research
Advancing Antimicrobial Innovation Through Science
About Natureza® Research
Advancing Antimicrobial Innovation Through Science
Natureza® was incorporated in 2009 as a Texas-based research and development company focused on antimicrobial science and formulation technologies. The company’s work builds on earlier research initiated through its affiliate, BioSafe Technologies, Inc., a Texas company founded in 2000, which provided early investment and technical support for the development of antimicrobial and antiparasitic formulations.
Natureza has evaluated multiple antimicrobial candidates as part of its research and development program. The company’s intellectual property portfolio includes issued U.S. and international patents, along with pending applications, covering antimicrobial formulations and related methods of use. Laboratory studies have demonstrated in-vitro activity against a broad range of Gram-positive and Gram-negative organisms, including several pathogens identified by the World Health Organization as priority threats.
These formulation-based systems have demonstrated antimicrobial activity in laboratory testing across 12 of the 15 organisms identified by the WHO as high concern. Under controlled experimental conditions, resistance development has not been observed, and the formulations have demonstrated favorable safety characteristics consistent with GRAS-designated components.
This work originated from earlier research conducted through BioSafe Technologies, which explored applications for controlling endoparasites and supporting wound and skin care. Subsequent studies expanded this work to include antimicrobial performance, formulation stability, and non-systemic applications relevant to environmental and topical use cases.
Natureza’s current efforts are focused on advancing these technologies through non-clinical evaluation, formulation optimization, and validation for targeted antimicrobial applications. The company continues to evaluate strategic opportunities for collaboration and licensing aligned with its platform-based development approach.

About BioSafe Technologies, Inc.
BioSafe Technologies, Inc.™ developed formulations for pesticide use from natural compounds discovered in South America to control ecto and endoparasites on humans and animals. Results from the UK and South America showed activity against parasites in addition to the enhanced healing of skin wounds, burns and bacteriostatic properties against Gram positive bacteria.
The company has been manufacturing and exporting a proprietary brand of head lice treatments for over two decades in the US and via several multinational pharmaceutical companies within established brands of children’s products. Business expanded digitally on Amazon.
Natureza’s Novelty of Formulations

Discover The Future
We are a multidisciplinary research laboratory focused on advancing antimicrobial formulation science through targeted discovery and applied research.